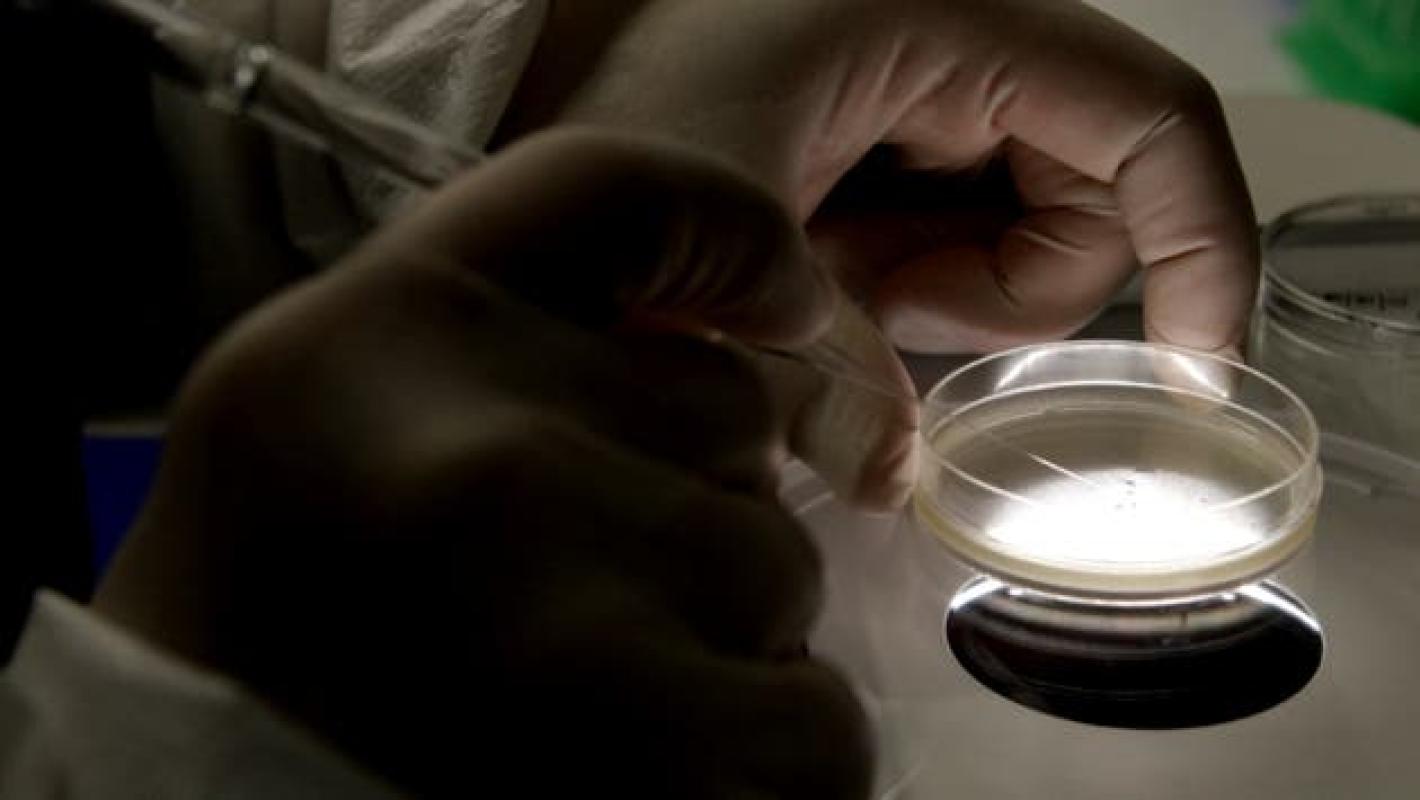

Crean el primer “cromosoma de diseño” a partir de levadura sintética
Crean el primer “cromosoma de diseño” a partir de levadura sintética
Crean el primer “cromosoma de diseño” a partir de levadura sintética
T13 En Vivo
Liderados por el especialista Jef Boeke, del Langone Medical Center de la Universidad de Nueva York, los expertos consiguieron generar la primera copia artificial de un cromosoma. En este caso de una levadura.
Por más de siete años se prolongó la investigación que permitió el logro científico, el cual se inició con los fragmentos disponibles de ADN, a los que fueron agregando otros mayores y finalmente las células de levadura de cerveza.
De acuerdo a un informe publicado este jueves en la revista Science, el hecho es considerado como un enorme hallazgo en lo que respecta a la biología sintética, que busca diseñar organismos.
Hay que destacar que ya se había podido construir cromosomas de virus y bacterias, pero esta es la primera vez que se logra generar uno para un organismo eucariótico, de mayor complejidad que los primeros.
Se prevé que este logro sirva para avanzar en la producción de nuevas medicinas y biocombustibles.










